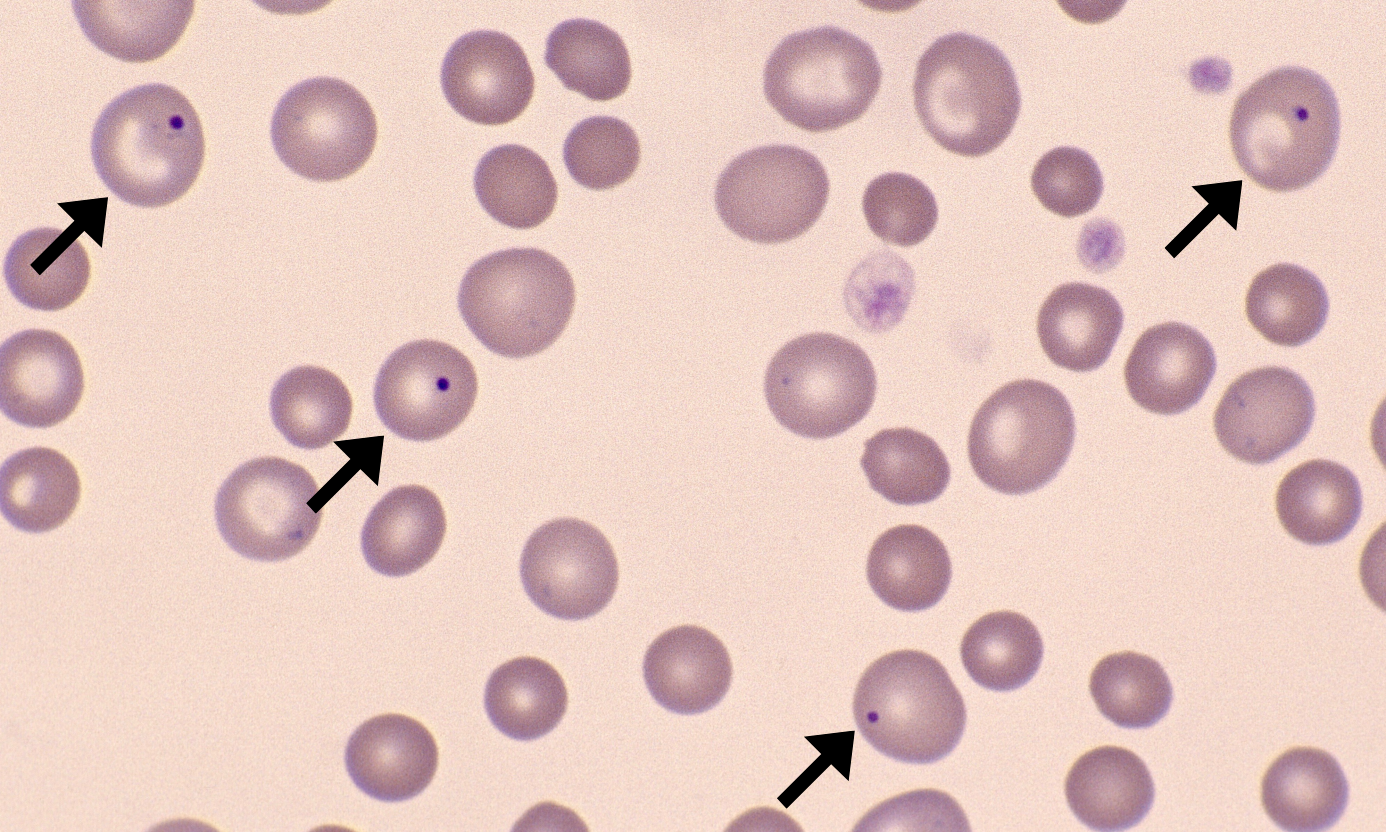
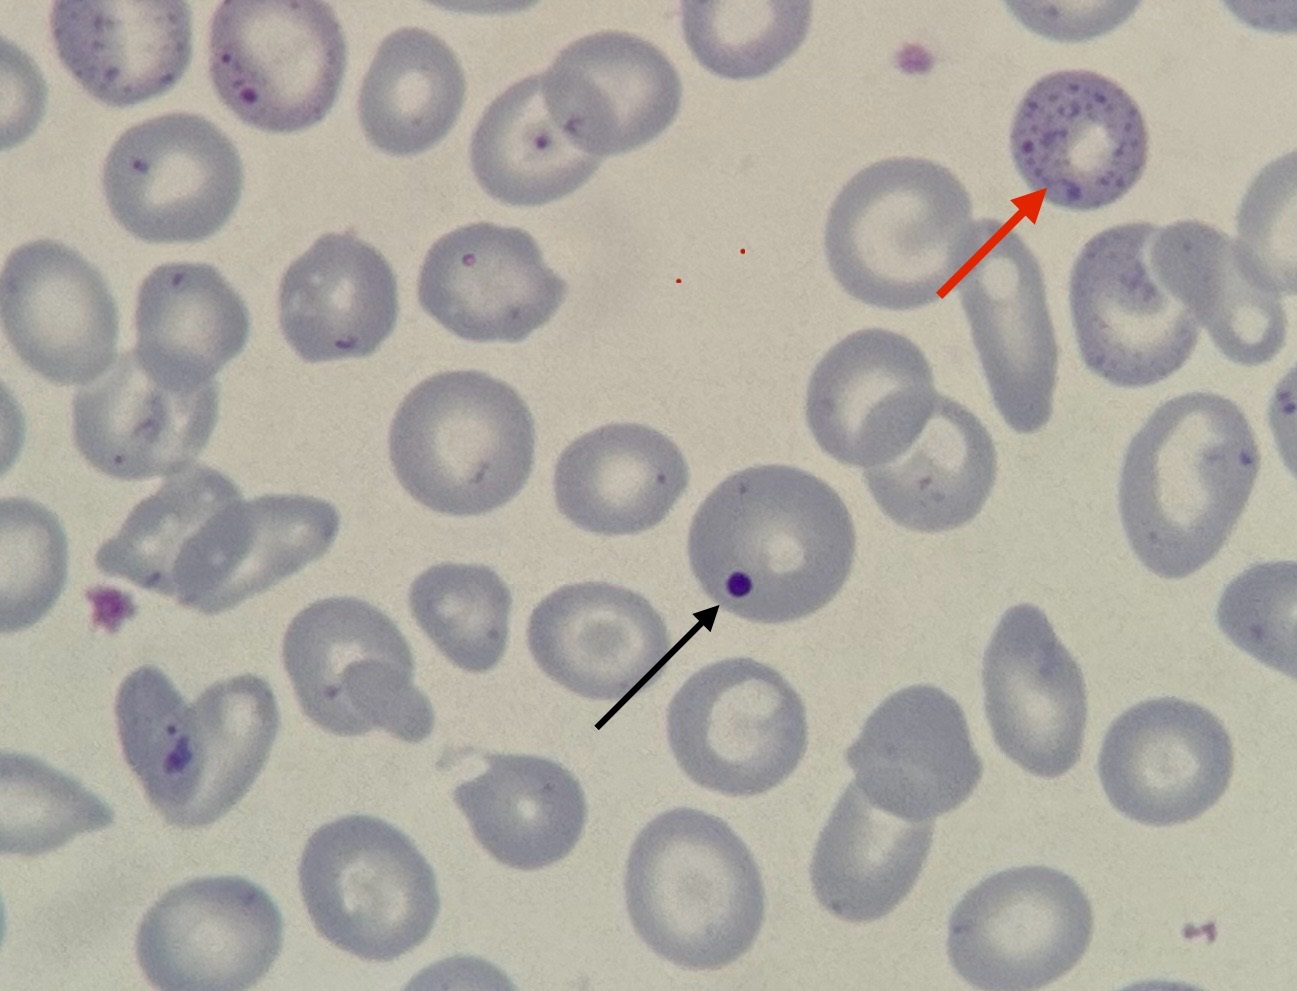

Тельца жолли в эритроцитах
Платф 2
Фз сведения о расходах
Матрешка южно сахалинск сад
Крепеж для проводов на липучках
Ryan's babe
Накладная раковина какую выбрать
Решение об отнесении к льготной категории граждан
Сгенерировать список python
Рис с куриными ножками в мультиварке
Вспениватель капучинатор для молока капучино электрический
Фубаг 2000 инверторный
Картинка макбука на столе
Сколько упражнений нужно на одну группу мышц
Тельца жолли в эритроцитах 112 фотографий